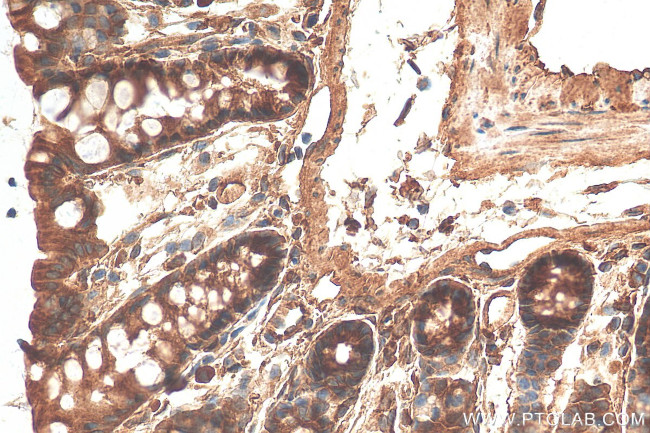
MYO5B Antibody in Immunohistochemistry (Paraffin) (IHC (P))

Search
Proteintech
MYO5B Polyclonal Antibody
{{$productOrderCtrl.translations['antibody.pdp.commerceCard.promotion.promotions']}}
{{$productOrderCtrl.translations['antibody.pdp.commerceCard.promotion.viewpromo']}}
{{$productOrderCtrl.translations['antibody.pdp.commerceCard.promotion.promocode']}}: {{promo.promoCode}} {{promo.promoTitle}} {{promo.promoDescription}}. {{$productOrderCtrl.translations['antibody.pdp.commerceCard.promotion.learnmore']}}
产品信息
29996-1-AP
种属反应
宿主/亚型
分类
类型
抗原
偶联物
形式
纯化类型
保存液
内含物
保存条件
运输条件
产品详细信息
Immunogen sequence: EFKTLSEQLS VTTSTYTMEV ERLKKELVHY QQSPGEDTSL RLQEEVESLR TELQRAHSER KILEDAHSRE KDELRKRVAD LEQENALLKD EKEQLNNQIL CQSKDEFAQN SVKENLMKKE LEEERSRYQN LVKEYSQLEQ RYDNLRDEMT IIKQTPGHRR NPSNQSSLES DSNYP
靶标信息
May be involved in vesicular trafficking via its association with the CART complex. The CART complex is necessary for efficient transferrin receptor recycling but not for EGFR degradation. Required in a complex with RAB11A and RAB11FIP2 for the transport of NPC1L1 to the plasma membrane. Together with RAB11A participates in CFTR trafficking to the plasma membrane and TF (transferrin) recycling in nonpolarized cells. Together with RAB11A and RAB8A participates in epithelial cell polarization. Together with RAB25 regulates transcytosis.
仅用于科研。不用于诊断过程。未经明确授权不得转售。
篇参考文献 (0)
生物信息学
蛋白别名: MYO5B variant protein; myosin 5B; Myosin heavy chain myr 6; Myosin of the dilute-myosin-V family; myosin-Vb; Unconventional myosin-Vb; unnamed protein product
基因别名: AI661750; DIAR2; KIAA1119; mKIAA1119; MVID1; MYO5B; Myr6; PFIC10
UniProt ID: (Human) Q9ULV0, (Rat) P70569
Entrez Gene ID: (Human) 4645, (Mouse) 17919, (Rat) 25132